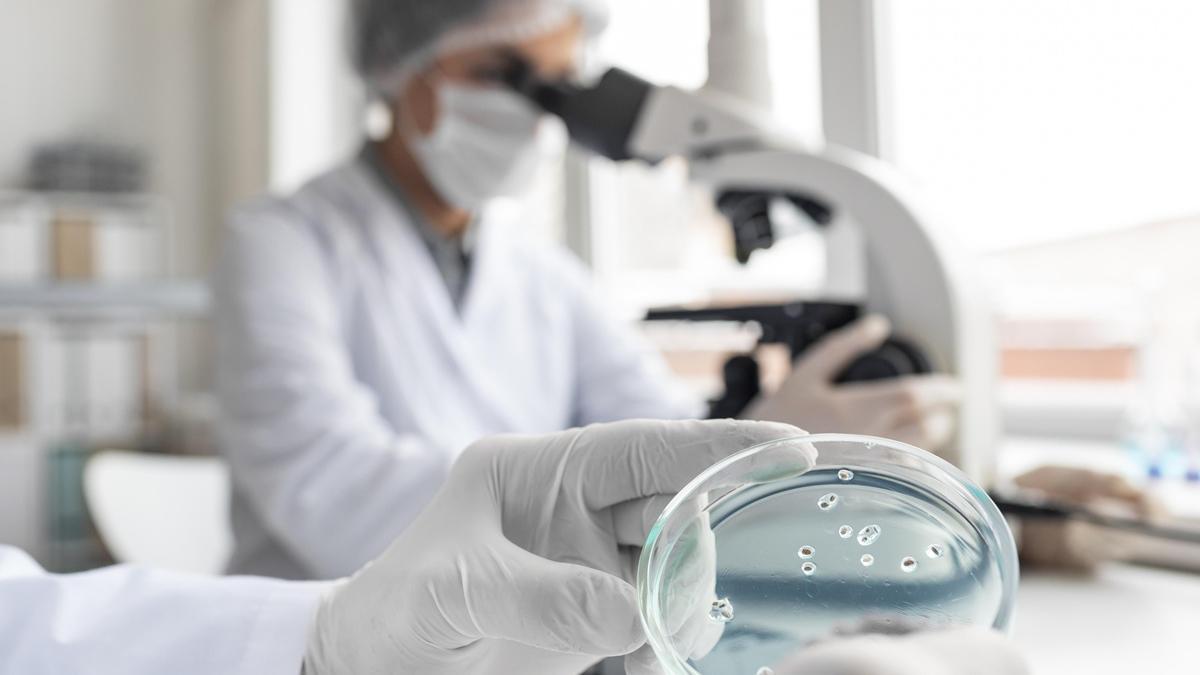

La estrategia, impulsada por el departamento de Salud de Gobierno vasco y fruto de un amplio proceso participativo iniciado en septiembre de 2024 con más de 400 profesionales, establece compromisos clave en prevención, detección precoz, itinerarios asistenciales integrados, investigación traslacional y protagonismo de profesionales y pacientes.
Además de consolidar el trabajo previo, se incorpora por primera vez la comunicación científica y la alfabetización social como pilares estructurales para mejorar los resultados en salud. El plan coincide con la aprobación de un nuevo impulso en políticas sanitarias y modelos organizativos, así como con la ambición de que Euskadi sea reconocida como centro integral de oncología de referencia en Europa.
Dentro del marco del lanzamiento, el consejero vasco de Salud, Alberto Martínez, anunció a principios de octubre la puesta en marcha de una Plataforma Única de Ensayos y Proyectos de Investigación en Oncología. La iniciativa, que representa un paso pionero para garantizar un acceso equitativo de los pacientes a los ensayos clínicos disponibles en Euskadi, busca reforzar la capacidad del sistema para atraer recursos y generar innovación en la lucha contra el cáncer.
El Plan Oncológico Integral de Euskadi y el Pacto Vasco de Salud establecen compromisos de planificación, asistencia, investigación y coordinación
ONCOBITES 2025
También en el marco del nuevo plan, el pasado 6 de octubre tuvo lugar en la Universidad de Deusto la jornada formativa ONCOBITES para fortalecer la colaboración entre periodismo y ciencia. Impulsado por el grupo académico de investigación clínica en cáncer, SOLTI, y dirigido a periodistas, el encuentro se celebró con el objetivo de contribuir a una comunicación rigurosa, comprensible y honesta sobre la investigación oncológica.
Profesionales de la comunicación médica, científica y de la salud se reunieron en torno a un programa que repasó los principales retos actuales en oncología, el desarrollo de fármacos innovadores, y los procesos de aprobación a nivel estatal, poniendo especial énfasis en el papel que debe desempeñar la comunicación científica para garantizar una información veraz y comprensible.
Las sesiones dieron comienzo con la intervención de la dra. María Ángeles Sala, oncóloga médica de la OSI Bilbao-Basurto y coordinadora corporativa del Plan Oncológico de Euskadi, quien resaltó la importancia de la cercanía con el paciente a la vez que reconoció el papel clave de una buena comunicación sanitaria para mejorar la calidad asistencial y humana.
La jornada continuó con una serie de presentaciones que abordaron el cáncer desde una mirada transversal. Carmen Peñafiel, catedrática de la Universidad del País Vasco (UPV-EHU), presidenta de la Asociación Española de Investigación de la Comunicación (AE-IC) y secretaria general del Colegio Vasco de Periodistas, destacó el papel clave del periodismo en la salud pública, defendiendo el valor de una información rigurosa y comprensible.
Actualmente, Euskadi cuenta con 140 proyectos de investigación activos y más de 12.000 pacientes implicados en ensayos clínicos relacionados con el cáncer
Desde el punto de vista científico, Arkaitz Carracedo, jefe de grupo en CIC bioGUNE, continuó con una ponencia centrada en los mecanismos moleculares del cáncer y la utilidad de los biomarcadores para personalizar los tratamientos. A continuación, la dra. Inés Marrodán, médica adjunta del servicio de oncología médica del Hospital Universitario de Cruces, abordó los principales hitos en el tratamiento del cáncer precoz, repasando las familias de fármacos que han transformado la oncología en la última década.
Por su parte, la dra. Elena Galve, oncóloga médica en el Hospital Universitario de Basurto, miembro de la junta directiva de SOLTI y de la sección de oncología de la Academia de Ciencias Médicas de Bilbao, centró su intervención en la enfermedad metastásica, destacando el impacto de las terapias dirigidas y la necesidad de adecuar la comunicación según el tipo de paciente y el estadio de la enfermedad.
Osakidetza ampliará el cribado de cáncer de mama en Euskadi a los 48 años
Por último, Isabel Pineros, PhD y directora del departamento de acceso de Farmaindustria, desgranó el proceso de evaluación, aprobación y acceso a fármacos oncológicos en España, poniendo el foco en los desafíos actuales para garantizar una innovación accesible y sostenible.
“El 70% de las mujeres que supera un cáncer de mama precoz no recae”
La dra. Elena Galve, oncóloga médica en el Hospital Universitario de Basurto, fue una de las participantes de ONCOBITES 2025 con una ponencia centrada en el cáncer de mama metastásico. La enfermedad metastásica o metástasis se produce cuando un cáncer empieza creciendo de manera local e invade los tejidos sanos de alrededor, los vasos sanguíneos y los vasos linfáticos. El cuerpo no es capaz de destruir esas células tumorales por lo que éstas llegan a un órgano a distancia, creciendo y formando la metástasis.
“Dentro del cáncer de mamá, hay tres grandes escenarios; cáncer de mama precoz, lo que llamamos localmente avanzado y cáncer de mama metastásico o avanzado. Cuando el cáncer de mama (células tumorales) se extiende fuera del área locorregional de la mama y afecta a otros órganos a distancia, es lo que se conoce como metástasis”, explica la doctora.
La mayoría de los tratamientos actuales que se están llevando a cabo son farmacológicos y traslacionales. Respecto a otras técnicas más innovadoras, el Hospital de Basurto y la empresa navarra NNBi han participado recientemente en un proyecto piloto con IA para evaluar la capacidad de los Grandes Modelos de Lenguaje (LLM – Large Language Models en inglés) en la clasificación de las toxicidades subjetivas de la quimioterapia, comparándolos con oncólogos expertos.
Mediante 15 casos ficticios, se ha demostrado que los LLM pueden alcanzar una precisión similar a la de los oncólogos en las categorías generales de toxicidad, aunque necesitan mejorarse en categorías específicas. Así, los resultados clave muestran una precisión del 81,5% en la clasificación de categorías de toxicidad general, y del 64,4% en la clasificación de categorías específicas.
En este sentido, la IA muestra un gran potencial para mejorar la monitorización de los pacientes y reducir la carga de trabajo de los profesionales de la salud. “El resultado ha dado una concordancia muy buena y la IA puede ayudar mucho pero aún no hemos dado el paso con pacientes. El objetivo final es poder hacer un seguimiento en casa y ser capaces de extraer un cuidado más continuo del paciente. Que cada día, la IA pueda hacer una síntesis de todo lo que le ha ocurrido en 2-3 semanas y que, con esta información, podamos trabajar en consulta”, afirma la oncóloga.
Además de la innovación, otro de los grandes retos de la oncología actual según la doctora – y que se va a trabajar en el nuevo plan - es la equidad. Que todo el mundo tenga las mismas oportunidades en el acceso a una medicina de precisión, a biomarcadores, así como a terapias innovadoras. La colaboración también supone un aspecto clave y, en este sentido, el Hospital de Basurto colabora en proyectos, formaciones y temas de oncología integrativa con asociaciones del territorio, así como con la Asociación Española contra el Cáncer.
Así, el hospital ha impulsado recientemente una plataforma (Asociaciones OSI Bilbao-Basurto) como canal de comunicación para que a través de una web (https://osi-bilbao-basurto.eus/osi/elkarteak/) los pacientes puedan tener acceso e información de las asociaciones. “Hemos empezado por oncología pero se acabará extendiendo a otras patologías”, concluye Galve.
Si tienes alguno de estos síntomas, acude a tu consulta de atención primaria:
- Cualquier bulto en la mama o en el ganglio axilar:
- Nódulos
- Cambios en la aureola o pezón
- Cambios en la piel de la mama
- Durezas
- Sangrado en el pezón